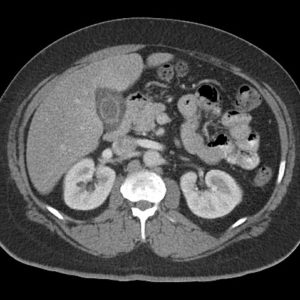
Viêm túi mật cấp

TIÊU HOÁ
Hiển thị 901–920 của 1445 kết quảĐã sắp xếp theo mới nhất
-

Viêm ruột hoại tử
Lượt xem: 741» 26-06-2019 -

Lồng ruột
Lượt xem: 202» 26-06-2019 -

Lồng ruột
Lượt xem: 189» 26-06-2019 -

Lồng ruột
Lượt xem: 154» 26-06-2019 -

Lồng ruột
Lượt xem: 187» 26-06-2019 -

Hẹp môn vị
Lượt xem: 244» 26-06-2019 -

Hẹp môn vị
Lượt xem: 138» 26-06-2019 -

Hẹp môn vị
Lượt xem: 224» 26-06-2019 -

Hẹp môn vị
Lượt xem: 168» 26-06-2019 -

Hẹp môn vị
Lượt xem: 145» 26-06-2019 -

Hẹp môn vị
Lượt xem: 152» 26-06-2019 -

Rò hậu môn
Lượt xem: 230» 17-06-2019 -

Rò hậu môn
Lượt xem: 264» 17-06-2019 -

Liposarcoma sau phúc mạc
Lượt xem: 235» 16-06-2019 -

Viêm ruột thừa
Lượt xem: 137» 16-06-2019 -

Viêm loét đại tràng
Lượt xem: 210» 15-06-2019 -

Viêm tụy hoại tử
Lượt xem: 305» 15-06-2019 -

Tăng sản nốt khu trú
Lượt xem: 155» 15-06-2019 -

U cơ tuyến túi mật
Lượt xem: 185» 15-06-2019 -

Viêm túi mật cấp
Lượt xem: 123» 14-06-2019